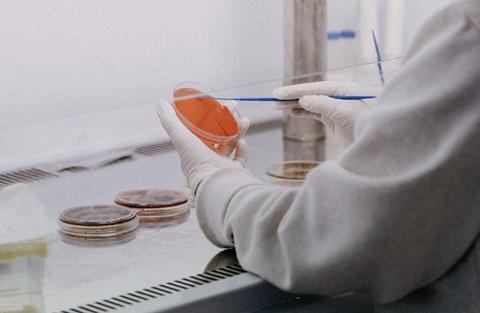

Close menu
- Home
- Shows
- Articles
- Connect
- Youth
- Books We Discuss
-
Topics
- Back to parent navigation item
- Topics
- Apologetics
- Art & imagination
- Atheism
- Bible: New Testament
- Bible: Old Testament
- Children & young people
- Christian living
- Church
- Culture
- Ethics
- Evangelism
- God
- History
- Jesus
- News & Events
- Other religions
- People & Influential Figures
- Philosophy
- Political
- Religious Seasons
- Science
- Sexuality & gender
- Social issues
- Suffering
- Technology
- Theology
- Wellbeing
- Donate
- Previous slide
- 1 of 1
- Next slide
- Topics A-Z
- Writers A-Z
- © 2025 Premier Christian Communications Ltd
Premier consists of Premier Christian Media Trust registered as a charity (no. 287610) and as a company limited by guarantee (no. 01743091) with two fully-owned trading subsidiaries: Premier Christian Communications Ltd (no. 02816074) and Christian Communication Partnership Ltd (no. 03422292). All three companies are registered in England & Wales with a registered office address of Unit 6 April Court, Sybron Way, Crowborough, TN6 3DZ.
Site powered by Webvision Cloud
















